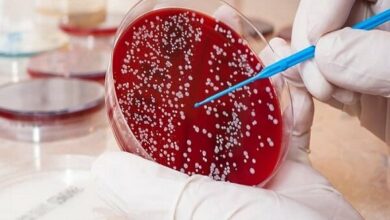

سلامت خانواده
-

با مصرف این ماده مغذی کلسترول خون را کاهش دهید
کشک سرشار از مواد معدنی مانند پتاسیم و منیزیم است که به تنظیم فشار خون کمک می کند. این مواد…
بیشتر بخوانید » -

کبد چرب ؛ یک مهمانی خاموش که بی سر و صدا پیشرفته است! – آژانس خبری مهر ایرانی و اخبار جهانی
Azita Hekmat ، متخصص تغذیه ، استاد تغذیه بالینی و استاد دانشگاه علوم پزشکی شهید بهشتتی ، به آژانس خبری…
بیشتر بخوانید » -

نگاه کنید به | شخص دیگری به جای پزشک عمل زیبایی را انجام می دهد. آیا پزشک می تواند روزانه جراحی کند؟
Mojtaba Wahhab ، متخصص جراحی زیبایی و پلاستیک ، در Cafe News به صورت آنلاین در مورد انجام جراحی زیبایی…
بیشتر بخوانید » -

درمان لوسمی در کودکان و احتمال بهبودی تا 5 ٪ – آژانس خبری مهر | اخبار ایرانی و جهانی
Gholamreza Bahavash Mehdi Abadi ، متخصص خون و سرطان متخصص اطفال ، به خبرگزاری مهر گفت: “لوسمی انواع مختلفی از…
بیشتر بخوانید » -

در تلاش برای حفظ سلامت شنوایی و گوش
گوش یکی از حساس ترین و حیاتی ترین اندام های بدن است که می تواند در حس شنوایی و تعادل…
بیشتر بخوانید » -

مراقب باشید “عروق معده” در کمین سلامت/ تفاوت بین آنفولانزای تنفسی چیست؟+ علائم و مراقبت ها
الهه ja'farzadeh: آنفولانزا معده یا معده که این بیماری دستگاه گوارش است که اغلب در اثر ویروس هایی مانند نورو…
بیشتر بخوانید » -

فواید مسواک زدن روی یک پا چیست؟!
مطابق با Isna News Online ، اگر می خواهید دو کار را همزمان انجام دهید. به عنوان مثال ، هنگام…
بیشتر بخوانید » -

ویتامین که یک سرپرست حافظه و سلامت مغز است
طبق اخبار آنلاین ، تحقیقات علمی نشان می دهد که این ویتامین نقش مهمی در حفظ سلامت شناختی ، کاهش…
بیشتر بخوانید » -

خوردن این میوه باعث می شود خواب شما منظم باشد
میوه های مرکبات نارنجی به دلیل حجم زیاد بتا کربن ، اعصاب را آرام می کنند و استرس و پریشانی…
بیشتر بخوانید » -

بهبود عملکرد مشترک با مصرف این نسخه ی نمایشی گیاهی
انواع گیاهان گلدار از خانواده شاهساندی ، بومی آمریکای جنوبی ، به طور طبیعی در آرژانتین ، شیلی و پرو…
بیشتر بخوانید »